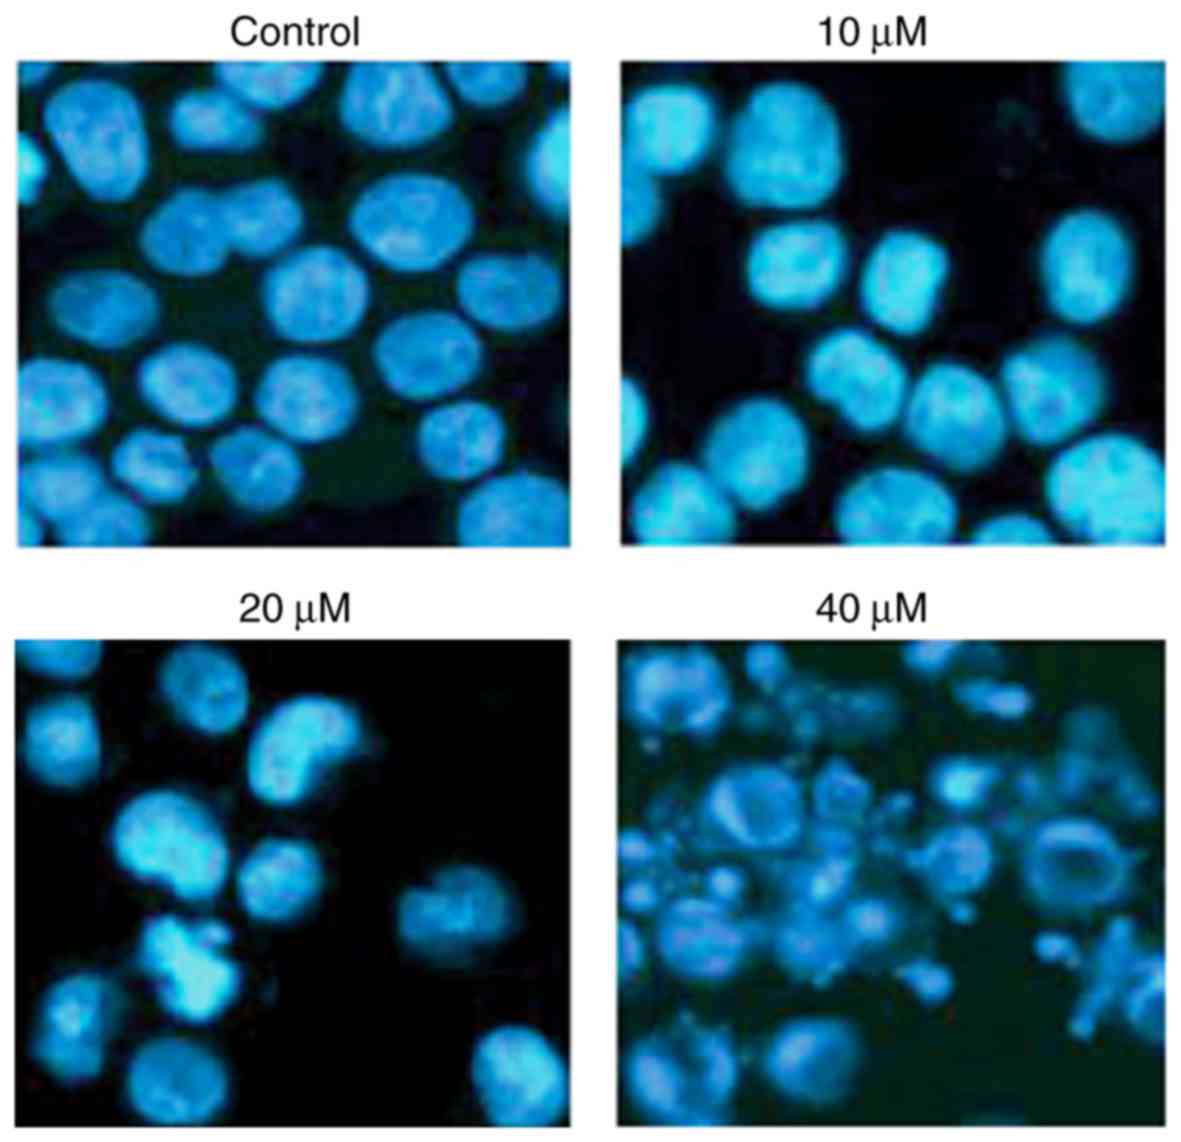

Introduction
Skin cancer is one among the primary causes of
mortality worldwide (1). It has
been previously estimated that ~1 in every 5 Americans will develop
skin cancer (2). The increasing
prevalence of skin cancer requires novel treatment options for the
management of skin cancer. Preliminary responses to chemotherapy
and/or surgical interventions are available; however, the
persistence of tumor relapse has been previously observed (3). In addition, the side effects
associated with synthetic drugs severely affect the quality of life
of patients. Drugs from natural sources have gained considerable
attention. Flavonoids form one of the largest groups of
plant-derived secondary metabolites that have evolved across the
plant kingdom billions of years ago. Flavonoids are an important
part of almost all edible plants, which include, but are not
limited to, fruits and vegetables. Therefore, flavonoids are
consumed in significant amounts as part of a healthy diet. It has
been previously reported that humans consume ~30 mg flavonoids
daily (4). Furthermore, flavonoids
are present in a number of medicinally important plants; herbal
preparations have been extensively used in traditional systems of
medicine, particularly in China (5). With advancements in medical research,
flavonoids are being investigated for variation in bioactivities.
These compounds have been reported to exhibit various
bioactivities, including anti-inflammatory, estrogenic, enzyme
inhibition, antimicrobial, anti-allergy, antioxidant and antitumor
(4,6). There is considerable epidemiological
evidence on the anticancer effects of flavonoids. A number of
epidemiological studies have indicated that high flavonoid intake
may be correlated with a reduced risk of cancer (7,8). As
these compounds have a fairly consistent structure, flavonoids
impede the activity of a wide range of eukaryotic enzymes;
therefore, they exhibit variation in activities. The structural
parts of flavonoid molecules have been considered critical for
their bioactivities (7,8). Additionally, flavonoids are
ubiquitously present in edible plants and beverages and are
believed to have minimal toxicity. The present study evaluated the
anticancer activity of a natural flavonoid, caffeic acid n-butyl
ester (CAE) in various cell lines. CAE exhibited the highest
activity against the A431 skin carcinoma cell line. CAE induced
A431 cell apoptosis, which may have been mediated by reactive
oxygen species (ROS) accretion and reductions in mitochondrial
membrane potential (MMP). Furthermore, CAE inhibited the expression
of some of the key proteins of phosphoinositide 3-kinase
(PI3K)/protein kinase B (AKT)/mechanistic target of rapamycin
(mTOR) signaling pathway, which has been considered an important
target for treatment of different types of cancers. Therefore, CAE
may be beneficial in the treatment and management of skin
carcinoma; however, further investigation is required.
Materials and methods
Chemicals and reagents
The following chemicals were used in the present
study. CAE, RNase A, Triton X-100 and dimethyl sulfoxide (DMSO),
were purchased from Sigma-Aldrich (Merck KGaA, Darmstadt, Germany).
Primary and secondary antibodies were obtained from Santa Cruz
Biotechnology, Inc. (Dallas, TX, USA). The fluorescent probes
DCFH-DA, DiOC6, DAPI, propidium iodide (PI), fetal bovine serum
(FBS), RPMI-1640 medium, L-glutamine and antibiotics were obtained
from Invitrogen (Thermo Fisher Scientific, Inc., Waltham, MA,
USA).
Cell line and culture conditions
Human lung cancer cell line (A549), pancreas (MIA
PaCa-2), prostate (PC-3), breast (MCF-7), gastric (SNU-5), colon
(HTB-39), normal human fibroblast FR2 and skin cancer (A431) cell
lines were obtained from the Cancer Research Institute of Beijing
(Beijing, China) and were cultured continuously in RPMI-1640
supplemented with 10% FBS containing antibiotics, 100 µg/ml
streptomycin and 100 U/ml penicillin G and maintained at 37°C and
5% CO2.
Proliferation assay
The anti-proliferative effects of CAE were
investigated in the 8 aforementioned cell lines using an MTT assay.
All cells were cultured at 37°C at a density of 1×106
cells/well in 96-well plates for 12 h. The cells were then
subsequently treated with 0–200 µM CAE for 24 h. Subsequently, 20
µl MTT solution was added to each well. Prior to the addition of
500 µl DMSO, the medium was completely removed. The MTT formazan
crystals were dissolved by adding 500 µl DMSO. The absorbance was
detected using an ELISA plate reader (optical density at 570 nm).
As CAE exhibited the lowest half-maximal inhibitory concentration
(IC50) against A431 cells, subsequent experiments were
conducted within this cell line at concentrations of 0, 10, 20 and
40 µM CAE.
Colony formation assay
The effect of CAE on the colony formation potential
of A431 cells was investigated when cells were collected at the
exponential phase of growth and the cells were then counted using a
hemocytometer. Cells were seeded at a density of 200 cells/well and
maintained at 37°C for 48 h to permit cell adherence. Subsequently,
0, 10, 20 and 40 µM CAE was administered. Following the treatment
with CAE, cells were incubated at 37°C for 6 days. Following
incubation, cells were washed with PBS and fixed with methanol at
−20°C for 4 min and then stained with crystal violet for 30 min at
room temperature, then counted under a light microscope
(magnification, ×200).
Detection of apoptosis
A431 cells were seeded at the density of
1×106 cells/well in 6-well plates and subsequently
treated with 0, 10, 20 and 40 µM CAE for 24 h, followed by DAPI
staining at 25°C for 5 min. Then, the cell samples were examined
via fluorescence microscopy (magnification, ×200).
Flow cytometry
A431 cells were plated at a density of
1×106 cells/well in 6-wellplates and treated with 0, 10,
20 and 40 µM CAE for 24 h. Subsequently, the cells were collected
and washed with PBS. The cells were then incubated with Annexin
V/FITC and PI for 15 min at 25°C, and apoptosis was estimated using
flow cytometry and BD FACSuite software v1.0 (BD Biosciences, San
Jose, CA, USA).
Cell cycle analysis
To investigate the dissemination of A431 cells in
different phases of the cell cycle, ~1×105 cells/well in
6-well plates were maintained at 37°C overnight to allow cell
adherence. Cells were then treated with 0, 10, 20 and 40 µM CAE and
then the plates were incubated at 37°C for 24 h. Subsequently, the
cells were trypsinized and resuspended in ice-cold PBS, followed by
treatment with ethanol (70%) and allowed to fix overnight at −20°C.
Following fixation with ethanol, cells were treated with ice-cold
PBS twice and subjected to centrifugation (800 × g) for 10 min at
4°C. Cells were then resuspended in 1 ml PI/Triton-X 100 solution
for 30 min in the dark. Finally, the dissemination of the cells at
each phase were examined using 8,000 cells in a FACScan flow
cytometer (BD Biosciences). The estimated percentage of cells in
each phase of the cell cycle was quantified using WinMDI
softwarev2.0 (Informer Technologies, Inc., Los Angeles, CA,
USA).
Determination of ROS and MMP
A431 cells were seeded at a density of
2×105 cells/well in a 6-well plate and maintained for 24
h at 37°C and treated with 0, 10, 20 and 40 µM CAEfor 24 h at 37°C
in 5% CO2 and 95% air. Subsequently, cells from all
samples were collected, washed twice with PBS and re-suspended in
500 µl DCFH-DA (10 µM) for ROS quantification or
3,3-dihexyloxacarbocyanine iodide (1 µmol/l) for MMP analysis at
37°C in a dark room for 30 min. The samples were then examined
instantly using a flow cytometer (WinMDI software version 2.0
(Informer Technologies, Inc.).
Cell migration assay
Cell migration analysis was performed using the
Boyden chamber assay with some modifications. Cells at the density
of 5×104 cells/well were suspended in RPMI-1640 medium
supplemented with 2% FBS and placed in the upper chamber of 8-µm
pore size Transwell inserts. Subsequently, RPMI-1640 medium medium
supplemented with 10% FBS was added to lower chamber, followed by
an incubation for 24 h at 37°C. On the upper surface of the
membrane, non-migrated cells were removed and migrated cells on the
lower surface of the membrane were fixed in 100% methanol and
Giemsa stained at 20°C for 4 h. Cell migration was estimated by
counting the number of the migrated cells under a microscope
(Olympus CH20i, Binocular version; Olympus Corporation, Tokyo,
Japan, magnification, ×200).
Western blotting analysis
Protein expression was determined by western blot
analysis. The cells were lysed in lysis buffer [20 mM
4-(2-hydroxyethyl)-1-piperazineethanesulphonic acid, 350 mM NaCl,
20% glycerol, 1% Nonidet P 40, 1 mM MgCl2, 0.5 mM EDTA,
0.1 mM EGTA, 1 mM DTT, 1 mM PMSF, protease inhibitor cocktail and
phosphatase inhibitor cocktail]. Briefly, proteins present in the
cell extracts were resolved by 10% SDS-PAGE. This was followed by
transfer on nitrocellulose membrane. The membrane was blocked with
5% non-fat milk in PBS and then incubated with primary antibody
primary antibody [AKT, sc-135829; phosphorylated (p)-AKT,
sc-7985-R; PI3K, sc-136298; mTOR, sc-517464 and p-mTOR, sc-293133]
for overnight at 4°C (all 1:1,000), followed by incubation with
horse radish peroxidase-conjugated (cat. no. 9003-99-0) and
anti-rabbit secondary antibody (sc-2372) for 1 h at room
temperature. All antibodies were purchased from purchased from
Santa Cruz Biotechnology, Inc. The western blots were visualized
using an enhanced chemiluminescence system (GE Healthcare, Chicago,
IL, USA). The western blots were quantified by my Image Analysis
software v1.0 (Thermo Fisher Scientific, Inc.).
Statistical analysis
The experiments were performed in triplicate and
data are presented as the mean ± standard deviation. Statistical
analysis was performed sing a one-way analysis of variance followed
by a Tukeys post-hoc test using GraphPad prism version 7 (GraphPad
Software, Inc. La Jolla CA, USA). P<0.05 was considered to
indicate statistically significant difference.
Results
Anticancer effects of CAE on the A431
cell
In order to investigate the anticancer effects of
CAE on various cancer cell lines, cells were treated with CAE at
various concentrations and the IC50 was determined for
each cell line (Table I). CAE
exhibited significant anticancer effects on A431 cells with an
observed IC50 of 20 µM. However, CAE exerted less
cytotoxic effects on normal human fibroblasts (Table I). The effect of CAE on the cell
viability demonstrated a dose-dependent manner (Fig. 1A). In addition, CAE treatment led
to reduced A431 colony formation in a dose-dependent manner
(Fig. 1B).
 | Table I.IC50 of CAE against
different cancer cell lines as determined by MTT assay. |
Table I.
IC50 of CAE against
different cancer cell lines as determined by MTT assay.
| Cell line | IC50
(µM) |
|---|
| Gastric cancer
SNU-5 |
30 |
| Lung cancer
A-549 |
30 |
| Skin cancer carcinoma
A431 |
20 |
| Prostate PC-3 |
30 |
| Breast MCF-7 |
40 |
| Pancreas MIA
PaCa-2 |
40 |
| Colon HTB-39 |
30 |
| Human normal
fibroblasts (FR2) | >100 |
CAE induces the apoptosis of A431
cells
To examine whether the anticancer effects of CAE
were due to the induction of apoptosis, A431 cells were treated
with CAE and apoptosis was determined by DAPI staining. The results
of the present study demonstrated that CAE induced A431 cell
apoptosis in a dose-dependent manner, as demonstrated by an
increase in the number of cells with white-colored nuclei (Fig. 2). The number of apoptotic cells was
determined using flow cytometry (Fig.
3). The percentage of apoptotic cells increased from 1.25% in
the control to 46.37% in the 40 µM CAE-treated group. In order to
determine examine whether apoptosis occurred following the
mitochondrial signalling pathway, the protein expression levels of
B-cell lymphoma 2 (Bcl-2) and BCL2-associated X(Bax) were
determined. The results of the present study revealed that the
protein expression of Bax was upregulated in a dose-dependent
manner, where as Bcl-2 expression levels were reduced with
increased CAE concentration (Fig.
4).
CAE induces the activation of ROS and
reduction of MMP
The pro-apoptotic potential of CAE observed via
Annexin V/FITC staining indicated that CAE induced accretion of
intracellular ROS. Therefore, the ROS levels in cells treated with
various doses of CAE for 24 h were investigated. The findings of
the present study revealed that the intracellular ROS levels of
CAE-treated cells increased by 210% in the 40 µM CAE-treated group
(Fig. 5A). These observations
indicated that CAE is an effective molecule that may stimulate the
accumulation of ROS within A431 cells to induce apoptosis.
ROS generation is associated with
mitochondrial dysfunction
ROS leads to an imbalance in the outer mitochondrial
potential resulting in the release of apoptosis-inducing proteins
(9). The effect of different CAE
doses on MMP in A431 cells was investigated in the present study.
CAE-treated A431 cells exhibited a marked reduction in MMP in a
dose-dependent manner. The MMP was reduced 42% within the 40 µM
CAE-treated group (Fig. 5B).
CAE induces cell cycle arrest
To examine the impact of CAE on the cell cycle phase
distribution of A431 cells, the cells were treated with 0, 10, 20
and 40 µM of CAE for 24 h. The number of cells in the G2 phase
increased in a dose-dependent manner leading to a cell cycle arrest
(Fig. 6). CAE-treatment of 40 µM
was associated with a marked increase in G2 phase cells.
CAE inhibits cell migration
The effects of CAE on cell migration of A431 cell
migration were investigated (Fig.
7). The results of cell migration assay following CAE treatment
(0, 10, 20 and 40 µM) for 24 h indicated that CAE reduced the
motility and migration of the of A431 cells in a dose-dependent
manner.
CAE targets the mTOR/PI3K/AKT
signaling pathway
The mTOR/PI3K/AKT signalling cascade is considered
to be one of the crucial pathways that maybe targeted for the
treatment of cancer (9). In the
present study, the effects of CAE on the expression levels of
important pathway proteins were investigated. The results
demonstrated that CAE-treated cells exhibited a dose-dependent
downregulation of mTOR and p-mTOR compared with untreated cells
(Fig. 8). In addition, PI3K/AKT
expression was also suppressed in response to CAE treatment.
Therefore, CAE may have exhibited an anticancer effect via the
mTOR/PI3K/AKT signalling cascade.
Discussion
Skin cancers are among the principal causes of
mortality in humans, particularly in the Caucasian population
(1). The increasing prevalence of
skin malignancies demands the development of novel treatment
strategies (1). Plants are
considered to be important source of anticancer drugs; therefore,
various natural compounds from plants have been used as anticancer
drugs (10). CAE is an important
flavonoid commonly found in several plant species and has been
previously reported to exhibit a marked pharmacological potential
(11). The anticancer effects of
CAE on cervix adenocarcinoma, oropharyngeal carcinoma, breast
cancer and melanoma have been previously reported (11). In the present study, the anticancer
activity of CAE was investigated in various human cancer cell lines
and normal human fibroblasts. The results indicated that CAE had a
potent inhibitory effect on the growth and colony forming potential
of A431 cells, as investigated via the proliferation and colony
formation assays respectively. It has been demonstrated that
various drugs inhibit growth by inducing apoptosis. For example,
multiple chemotherapeutic agents, including cisplatin, taxol and
5-fluorouracil (11,12) have been reported to alter specific
apoptotic signalling pathways. In addition, the resistance of the
cancer cells to a particular drug maybe partially due to the
ability to inhibit apoptosis (13). To examine whether CAE induces the
apoptosis of A431 cells, the CAE-treated cells were subjected to
DAPI staining. The results of the present study revealed that CAE
induced apoptosis in a dose-dependent manner. In addition,
CAE-treated cells demonstrated a reduction in ROS-induced MMP
(Fig. 5). The results of the
present study are supported by previous investigations (14,15);
CAE may induce apoptosis damage via the accretion of high ROS
levels and a reduction in MMP. It has been previously reported that
numerous anticancer drugs exert cytotoxic effects on cancer cells
via the generation of ROS (15).
Furthermore, mitochondria have an important role in ROS. Capsaicin
imbalances MMP and mediates oxidative stress leading to apoptosis
in pancreatic cancer cells (16).
The findings of the present study may contribute to the development
of skin cancer treatments as this type of cancer has been reported
to exhibit high rates of mortality (17). The effects of CAE on the protein
expression levels of mTOR, p-mTOR, PI3K, p-PI3K and AKT were
determined using western blot analysis. In addition, CAE-treated
cells exhibited a dose-dependent inhibition of mTOR and p-mTOR
protein expression and a reduction in PI3K/AKT protein
expression.
In conclusion, the findings of the present study
indicated that CAE may be a potential treatment for skin cancer by
targeting the mTOR/PI3K/AKT signaling cascade. As available
treatment options are limited, naturally occurring CAE may be
considered a potential treatment for skin cancer due to its
associated low toxicity; however, further investigation in
vivo is required.
References
|
1
|
de Gruijl FR: Skin cancer and solar UV
radiation. Eur J Cancer. 35:2003–2009. 1999. View Article : Google Scholar : PubMed/NCBI
|
|
2
|
Donaldson MR and Coldiron BM: No end in
sight: The skin cancer epidemic continues. Semin Cutan Med Surg.
30:3–5. 2011. View Article : Google Scholar : PubMed/NCBI
|
|
3
|
Aitken JF, Elwood M, Baade PD, Youl P and
English D: Clinical whole-body skin examination reduces the
incidence of thick melanomas. Int J Cancer. 126:450–458. 2010.
View Article : Google Scholar : PubMed/NCBI
|
|
4
|
Hollman PC and Katan MB: Dietary
flavonoids: Intake, health effects and bioavailability. Food Chem
Toxicol. 37:937–942. 1999. View Article : Google Scholar : PubMed/NCBI
|
|
5
|
Nagaoka T, Banskota AH, Tezuka Y, Saiki I
and Kadota S: Selective antiproliferative activity of caffeic acid
phenethyl ester analogues on highly livermetastatic murine colon
26-L5 carcinoma cell line. Bioorg Med Chem. 10:3351–3359. 2002.
View Article : Google Scholar : PubMed/NCBI
|
|
6
|
Takagaki N, Sowa Y, Oki T, Nakanishi R,
Yogosawa S and Sakai T: Apigenin induces cell cycle arrest and
p21/WAF1 expression in a p53-independent pathway. Inter J Oncol.
26:185–190. 2005.
|
|
7
|
Le Marchand L: Cancer preventive effects
of flavonoids-A review. Biomed Pharmacother. 56:296–301. 2002.
View Article : Google Scholar : PubMed/NCBI
|
|
8
|
Alonso DF, Farías EF, Urtreger A, Ladeda
V, Vidal CC and Bal De Kier Joffe E: Characterization of F3II, a
sarcomatoid mammary carcinoma cell line originated from a clonal
subpopulation of a mouse adenocarcinoma. J Surg Oncol. 62:288–297.
1996. View Article : Google Scholar : PubMed/NCBI
|
|
9
|
Tapia O, Riquelme I, Leal P, Sandoval A,
Aedo S, Weber H, Letelier P, Bellolio E, Villaseca M, Garcia P and
Roa JC: The PI3K/AKT/mTOR pathway is activated in gastric cancer
with potential prognostic and predictive significance. Virchows
Arch. 465:25–33. 2014. View Article : Google Scholar : PubMed/NCBI
|
|
10
|
Azuma M, Tamatani T, Ashida Y, Takashima
R, Harada K and Sato M: Cisplatin induces apoptosis in oral
squamous carcinoma cells by the mitochondria-mediated but not the
NF-kappaB-suppressed pathway. Oral Oncol. 39:282–289. 2003.
View Article : Google Scholar : PubMed/NCBI
|
|
11
|
Cárdenas M, Marder M, Blank VC and Roguin
LP: Roguin. Antitumor activity of some natural flavonoids and
synthetic derivatives on various human and murine cancer cell
lines. Bioorg Med Chem. 14:2966–2971. 2004. View Article : Google Scholar
|
|
12
|
Yoneda K, Yamamoto T and Osaki T: p53- and
p21-independent apoptosis of squamous cell carcinoma cells induced
by 5-fluorouracil and radiation. Oral Oncol. 34:529–537. 1998.
View Article : Google Scholar : PubMed/NCBI
|
|
13
|
Ferreira CG, Epping M, Kruyt FA and
Giaccone G: Apoptosis: Target of cancer therapy. Clin Cancer Res.
8:2024–2034. 2002.PubMed/NCBI
|
|
14
|
Ding H, Han C, Guo D, Chin YW, Ding Y,
Kinghorn AD and DAmbrosio SM: Selective induction of apoptosis of
human oral cancer cell lines by avocado extracts via a ROS-mediated
mechanism. Nutr Cancer. 61:348–356. 2009. View Article : Google Scholar : PubMed/NCBI
|
|
15
|
Trachootham D, Alexandre J and Huang P:
Targeting cancer cells by ROS-mediated mechanisms: A radical
therapeutic approach? Nat Rev Drug Discov. 8:579–591. 2009.
View Article : Google Scholar : PubMed/NCBI
|
|
16
|
Pramanik KC, Boreddy SR and Srivastava SK:
Role of mitochondrial electron transport chain complexes in
capsaicin mediated oxidative stress leading to apoptosis in
pancreatic cancer cells. PLoS One. 6:e201512011. View Article : Google Scholar : PubMed/NCBI
|
|
17
|
Elwood JM, Lee JA, Walter SD, Mo T and
Green AE: Relationship of melanoma and other skin cancer mortality
to latitude and ultraviolet radiation in the United States and
Canada. Int J Epidemiol. 3:325–332. 1974. View Article : Google Scholar : PubMed/NCBI
|